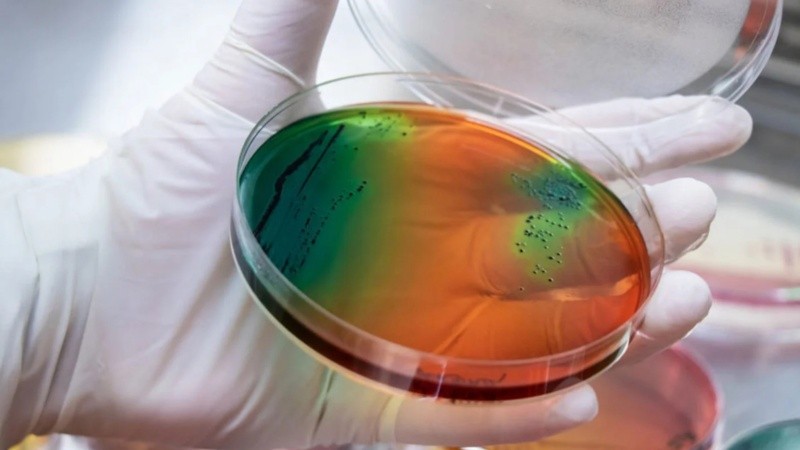
La misma se celebra cada año, del 18 al 24 de noviembre.

A través del lema "Prevengamos juntos la resistencia a los antimicrobianos", el mismo que se utilizó en 2022; la Organización Panamericana de la Salud (OPS) junto a otras organizaciones y asociaciones a nivel internacional, conmemoran la Semana Mundial de la Concientización sobre la Resistencia a los Antimicrobianos (WAAW, según su nombre en inglés), del 18 al 24 de noviembre.
Semana Mundial de la Concientización sobre la Resistencia a los Antimicrobianos
La resistencia a los antimicrobianos (RAM) es una amenaza tanto para los seres humanos como así también para animales, plantas y medioambiente en general. "Nos afecta a todos", subrayan desde el sitio web oficial de la OPS.
Por tal motivo, el lema escogido busca fomentar la colaboración de todos los sectores para preservar la eficacia de los antimicrobianos. Es decir, debe abordarse desde un enfoque interdisciplinario e intersectorial.
En tal sentido, señalan que el uso de antimicrobianos debe ser prudente, al igual que las medidas preventivas. "Reforzar la prevención y el control de las infecciones en centros hospitalarios, controlar explotaciones agrícolas e instalaciones de la industria alimentaria; garantizar el acceso a las vacunas, agua potable, saneamiento e higiene implementando mejores prácticas en la producción alimentaria y agrícola, y garantizar la buena gestión de los residuos y aguas residuales de las industrias pertinentes son fundamentales para reducir la necesidad de antimicrobianos y minimizar la aparición y transmisión de la resistencia a los mismos", explican.
Una problemática seria
La resistencia a los antimicrobianos (RAM) surge cuando las bacterias, los virus, los hongos y los parásitos dejan de responder a los agentes antimicrobianos. Como consecuencia de la farmacorresistencia, los antibióticos y otros agentes antimicrobianos se vuelven ineficaces y las infecciones se tornan difíciles o imposibles de tratar, lo que incrementa el riesgo de propagación de enfermedades, de aparición de formas graves de estas y mayor mortalidad, sgún señala la Organización Mundial de la Salud.
Esto puede suceder en infecciones respiratorias, gastrointestinales, de vías urinarias, heridas de la piel, entre otras. La problemática es tan real, que las bacterias resistentes y multirresistentes causan más muertes que el VIH, la malaria y ciertos tipos de cáncer.
La principal causa de la resistencia a los antimicrobianos (que amenaza a los seres humanos, los animales, las plantas y el medio ambiente) es el uso indebido y excesivo de los antimicrobianos, tanto para la salud humana como para la producción de alimentos, y por ello es fundamental que las comunidades conozcan sobre resistencia la RAM y se motiven a modificar sus hábitos, evitar la automedicación, consultar los servicios de salud a tiempo y seguir las pautas recomendadas de tratamiento en cuanto a dosis, tiempos y duración.
Es tal su impacto e importancia que la Organización Mundial de la Salud la considera uno de los 10 problemas sanitarios urgentes de dimensión mundial, junto con la contaminación del aire y el cambio climático, e incluso se habla de una "pandemia silenciosa".